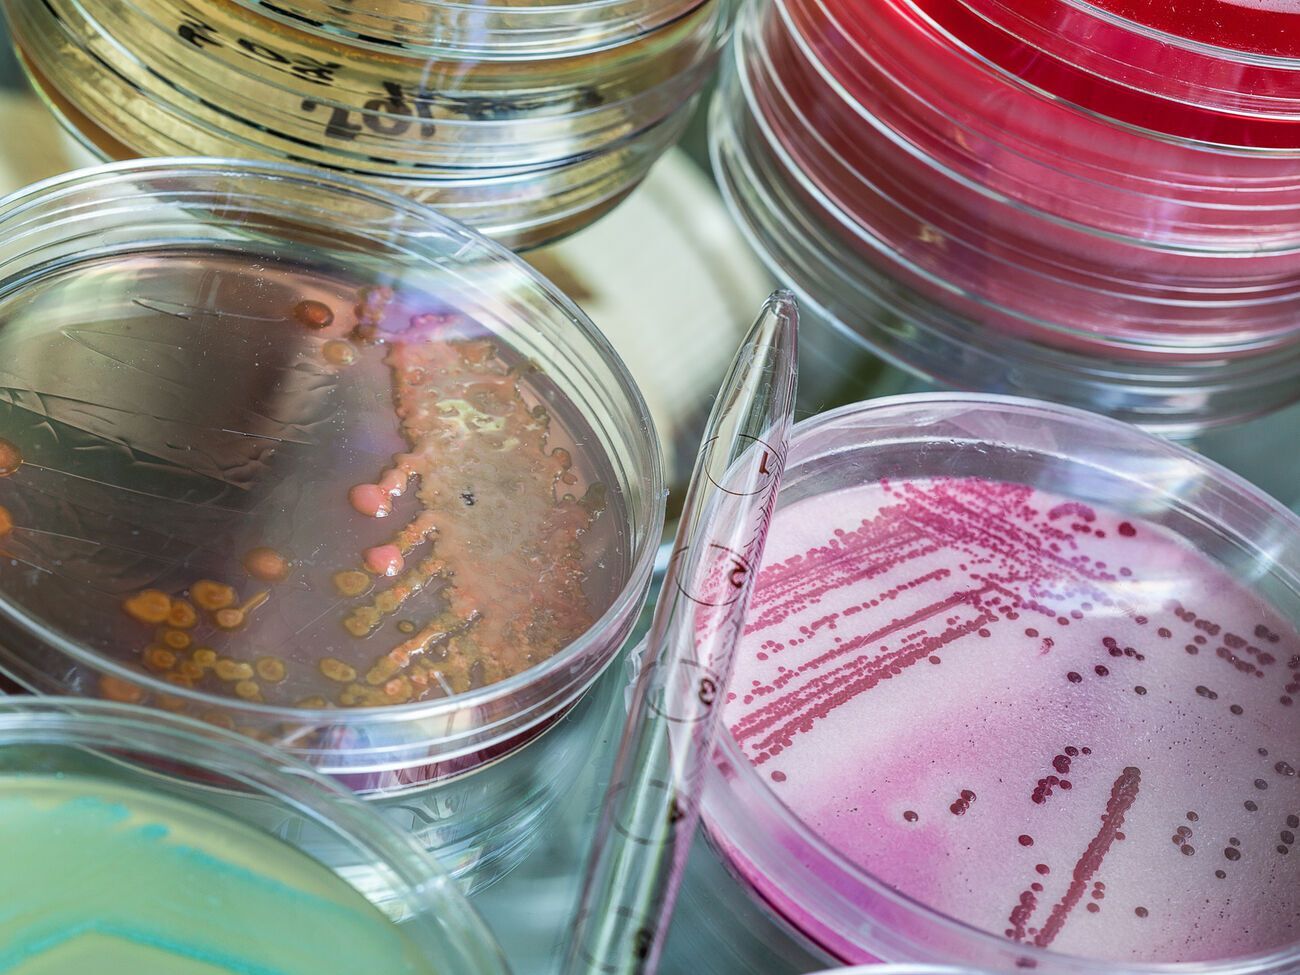
Россия может попытаться обвинить Украину в&nbsp;"применении биологического оружия", считают в ГУР

Игорь Конашенков


29 ноября, 19.02
Война в Украине
1 августа, 23.19
Война в Украине
23 июля, 12.41
Война в Украине
16 июня, 16.10
Война в Украине
17 мая, 09.14
Война в Украине
В Минобороны Украины высмеяли заявления минобороны РФ об уничтожении ЗРК Patriot
16 мая, 20.26
Война в Украине
10 апреля, 17.55
Война в Украине
17 марта, 12.23
Мир
23 января, 10.52
Мир
5 января, 14.41
Война в Украине
3 января, 23.38
Война в Украине
В минобороны РФ назвали вероятное бегство из Херсона "маневром", а не отступлением
10 ноября, 14.08
Война в Украине
10 сентября, 17.52
Война в Украине
Минобороны РФ умолчало об отступлении из Балаклеи и закрыло комментарии в соцсетях
10 сентября, 13.37
Война в Украине
23 августа, 13.21
Общество
1 августа, 08.13
Война в Украине
30 июня, 17.39
Война в Украине
3 мая, 19.30
Политика
2 мая, 18.39
Война в Украине
15 апреля, 22.57
Война в Украине
13 апреля, 21.04
Мир
8 апреля, 00.32
Война в Украине
22 марта, 02.58
Война в Украине
ВСУ подтвердили ракетный удар оккупантов по складу боеприпасов в Ивано-Франковской области
19 марта, 14.56
Война в Украине
15 марта, 12.59
Блоги
11 марта, 02.05
Война в Украине
11 марта, 00.34
Война в Украине
10 марта, 12.36
БлогиПредыдущая
Следующая

